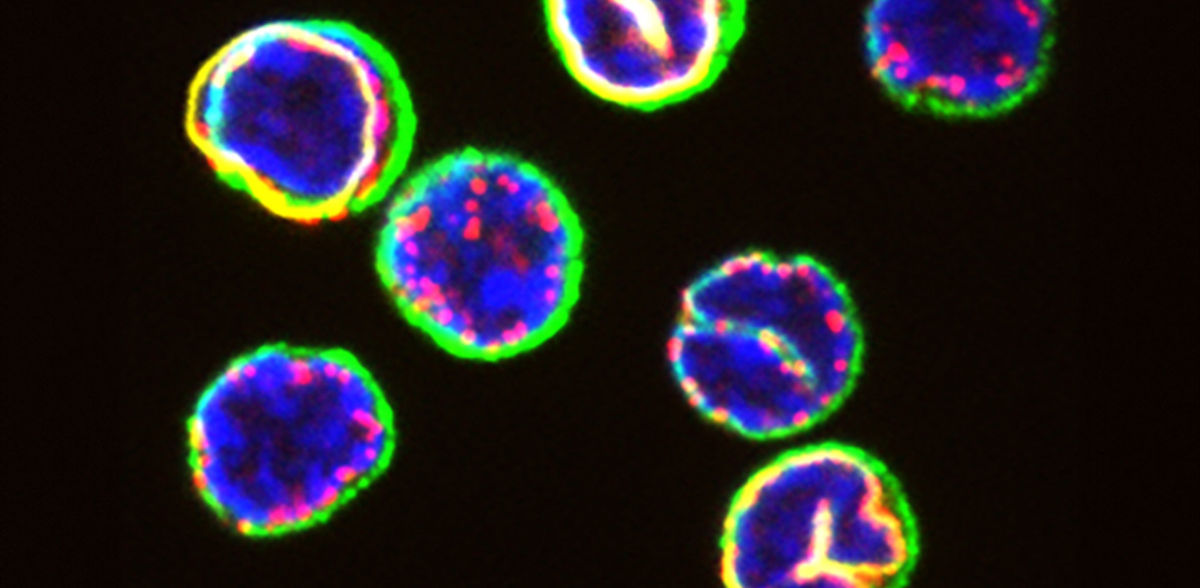

Los investigadores identifican diferencias clave en el funcionamiento interno de las células inmunitarias
Además de mejorar nuestra comprensión del sistema inmunitario, estos descubrimientos también podrían conducir a mejores terapias contra el cáncer
Anuncios
Utilizando métodos de aprendizaje automático, investigadores de la ETH de Zúrich han demostrado que más de la mitad de las células T asesinas presentan invaginaciones nucleares, o pliegues en la envoltura nuclear de la célula. Gracias a esta particular arquitectura celular, estas células son capaces de montar una respuesta más rápida y más fuerte a los patógenos.
Desde fuera, la mayoría de las células T tienen el mismo aspecto: pequeñas y esféricas. Ahora, un equipo de investigadores dirigido por Berend Snijder, del Instituto de Biología de Sistemas Moleculares de la ETH de Zúrich, ha observado más de cerca el interior de estas células utilizando técnicas avanzadas. Sus hallazgos demuestran que la organización espacial subcelular de las células T citotóxicas -lo que Snijder denomina su arquitectura celular- tiene una gran influencia en su destino.
Características que determinan el destino de una célula
Cuando las células con invaginaciones nucleares se encuentran con un patógeno, se convierten en potentes células efectoras que proliferan rápidamente y matan al patógeno. Sus compañeras con núcleo esférico, es decir, sin invaginaciones nucleares, evolucionan a un ritmo más pausado: tardan más en activarse y acaban diferenciándose en células de memoria longevas que defienden al organismo de futuros ataques del mismo patógeno.
Los científicos identificaron estas dos poblaciones de células T funcionalmente distintas hace unos 50 años. "Pero hasta ahora no sabíamos con certeza qué características determinaban que una célula T se convirtiera en una célula efectora o en una célula de memoria", explica Ben Hale, investigador postdoctoral del grupo de Snijder y autor principal del artículo publicado recientemente en la revista Science.
Para ayudar a identificar estas características, los investigadores desarrollaron una plataforma que analiza automáticamente imágenes microscópicas de células inmunitarias. A continuación, presentaron esta plataforma con miles de células T de 24 voluntarios sanos que donaron su sangre al Servicio de Donación de Sangre de Zúrich de la Cruz Roja Suiza.
Diferencias inesperadas
Mediante un método de aprendizaje automático, la plataforma clasificó las células en tres grupos diferentes. "Ya habíamos visto cómo algunas células T tienen forma de botella cuando se activan", explica Snijder. "Pero no esperábamos que la plataforma dividiera las células redondas en dos grupos diferentes".
Al investigar más a fondo, los investigadores también descubrieron que las diferencias en la arquitectura celular entre las dos clases de células redondas también tienen un significado funcional. "Las células con invaginaciones nucleares están diseñadas para activarse rápidamente: muchas de ellas se convierten en células efectoras con forma de botella en 24 horas", afirma Hale.
"También montan una respuesta más fuerte cuando se activan, y proliferan mucho más rápido que las células sin invaginaciones nucleares", añade Snijder. Él y su equipo también identificaron el mecanismo molecular que conduce a la activación más rápida y potente de las células con invaginaciones nucleares: "Su arquitectura celular especial permite una mayor afluencia de iones de calcio", afirma Snijder.
Ambos investigadores subrayan que aún quedan muchas preguntas por responder. Por ejemplo, Snijder y su equipo esperan descubrir ahora cómo consigue el organismo que alrededor del 60 por ciento de las células T citotóxicas de la sangre tengan invaginaciones nucleares, mientras que el 35 por ciento no las tienen y el 5 por ciento restante tienen forma de botella.
Aumentar la eficacia clínica de las terapias
Snijder y Hale señalan que sus resultados no sólo son "importantes para comprender mejor cómo funcionan nuestras células inmunitarias", sino que también desempeñan un papel crucial en la lucha contra el cáncer, por ejemplo: "Muchas terapias novedosas utilizan células T para eliminar células cancerosas", afirma Snijder. "Si encontramos la manera de seleccionar y desplegar específicamente estas arquitecturas celulares, quizá podamos mejorar la eficacia clínica de tales terapias".
Nota: Este artículo ha sido traducido utilizando un sistema informático sin intervención humana. LUMITOS ofrece estas traducciones automáticas para presentar una gama más amplia de noticias de actualidad. Como este artículo ha sido traducido con traducción automática, es posible que contenga errores de vocabulario, sintaxis o gramática. El artículo original en Inglés se puede encontrar aquí.
Publicación original
Benjamin D. Hale, Yannik Severin, Fabienne Graebnitz, Dominique Stark, Daniel Guignard, Julien Mena, Yasmin Festl, Sohyon Lee, Jacob Hanimann, Nathan S. Zangger, Michelle Meier, David Goslings, Olga Lamprecht, Beat M. Frey, Annette Oxenius, Berend Snijder; "Cellular architecture shapes the naïve T cell response"; Science, Volume 384